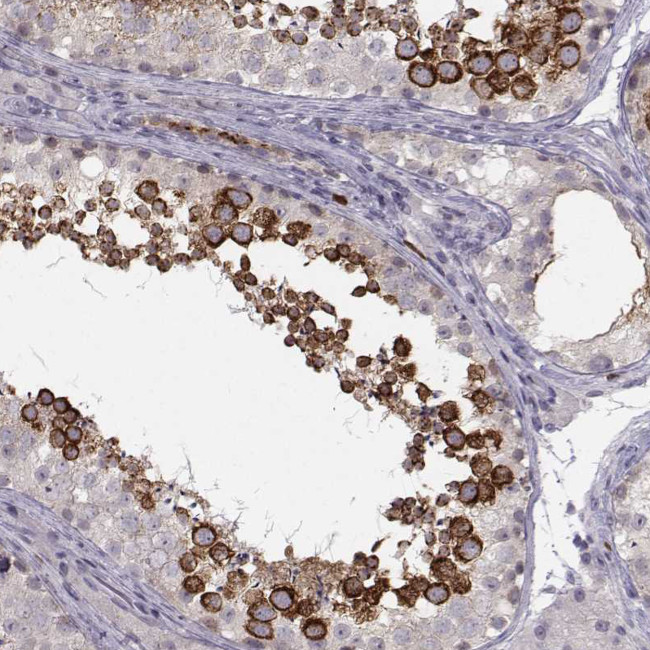
LRP8 Antibody in Immunohistochemistry (Paraffin) (IHC (P))

Search
Invitrogen
LRP8 Polyclonal Antibody
{{$productOrderCtrl.translations['antibody.pdp.commerceCard.promotion.promotions']}}
{{$productOrderCtrl.translations['antibody.pdp.commerceCard.promotion.viewpromo']}}
{{$productOrderCtrl.translations['antibody.pdp.commerceCard.promotion.promocode']}}: {{promo.promoCode}} {{promo.promoTitle}} {{promo.promoDescription}}. {{$productOrderCtrl.translations['antibody.pdp.commerceCard.promotion.learnmore']}}
产品信息
PA5-111706
种属反应
宿主/亚型
分类
类型
抗原
偶联物
形式
浓度
规格
纯化类型
保存液
内含物
保存条件
运输条件
RRID
产品详细信息
Immunogen sequence: HIGRTAQIGH VYPAAISSFD RPLWAEPCLG ETREPEDPAP ALKELFVLPG EPRSQLHQLP KNPLSELPVV KSKRVALSLE DDGLP
Highest antigen sequence indentity to the following orthologs: Rat - 26%, Mouse - 94%.
靶标信息
Apolipoprotein E receptor 2 (ApoER2) is an NMDA associated protein found in neurons. It participates in important functions from guiding neurons in the embryonic brain to regulating synaptic signaling. It is also involved in debilitating neurodegenerative diseases such as schizophrenia and Alzheimer's disease.
仅用于科研。不用于诊断过程。未经明确授权不得转售。
篇参考文献 (0)
生物信息学
蛋白别名: ApoE receptor 2; Apolipoprotein E receptor 2; low density lipoprotein receptor-related protein 8, apolipoprotein e receptor; Low-density lipoprotein receptor-related protein 8; LRP-8; unnamed protein product
基因别名: APOER2; HSZ75190; LRP-8; LRP8; MCI1
UniProt ID: (Human) Q14114
Entrez Gene ID: (Human) 7804